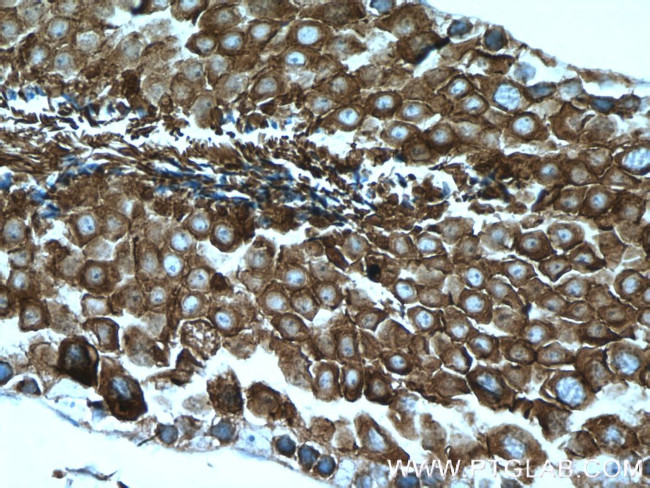
CAMSAP2 Antibody in Immunohistochemistry (Paraffin) (IHC (P))

Search
Proteintech
CAMSAP2 Polyclonal Antibody
{{$productOrderCtrl.translations['antibody.pdp.commerceCard.promotion.promotions']}}
{{$productOrderCtrl.translations['antibody.pdp.commerceCard.promotion.viewpromo']}}
{{$productOrderCtrl.translations['antibody.pdp.commerceCard.promotion.promocode']}}: {{promo.promoCode}} {{promo.promoTitle}} {{promo.promoDescription}}. {{$productOrderCtrl.translations['antibody.pdp.commerceCard.promotion.learnmore']}}
产品信息
17880-1-AP
种属反应
已发表种属
宿主/亚型
分类
类型
抗原
偶联物
形式
浓度
规格
纯化类型
保存液
内含物
保存条件
运输条件
产品详细信息
Immunogen sequence: KADVPVEKY DGESDKEQFD DDQKVCCGFF FKDDQKAEND MAMKRAALLE KRLRREKETQ LRKQQLEAEM EHKKEETRRK TEEERQKKED ERARREFIRQ EYMRRKQLKL MEDMDTVIKP RPQVVKQKKQ RPKSIHRDHI ESPKTPIKGP PVSSLSLASL NTGDNESVHS GKRTPRSESV EGFLSPSRCG SRNGEKDWEN ASTTSSVASG TEYTGPKLYK EPSAKSNKHI IQNALAHCCL AGKVNEGQKK KILEEMEKSD ANNFLILFRD SGCQFRSLYT YCPETEEINK LTGIGPKSIT KKMIEGLYKY NSDRKQFSHI PAKTLSASVD AITIHSHLWQ TKRPVTPKKL LPTKA (551-904 aa encoded by BC065508)
靶标信息
CAMSAP2 gene ontology annotations related to this gene include neuron projection development.
仅用于科研。不用于诊断过程。未经明确授权不得转售。
生物信息学
蛋白别名: calmodulin regulated spectrin-associated protein 1-like 1; Calmodulin-regulated spectrin-associated protein 1-like protein 1; Calmodulin-regulated spectrin-associated protein 2; unnamed protein product
基因别名: 1600013L13Rik; 4930541M15Rik; CAMSAP1L1; CAMSAP2; KIAA1078; mKIAA1078; RGD1310950
UniProt ID: (Human) Q08AD1, (Mouse) Q8C1B1, (Rat) D4AEC2
Entrez Gene ID: (Human) 23271, (Mouse) 67886, (Rat) 289400